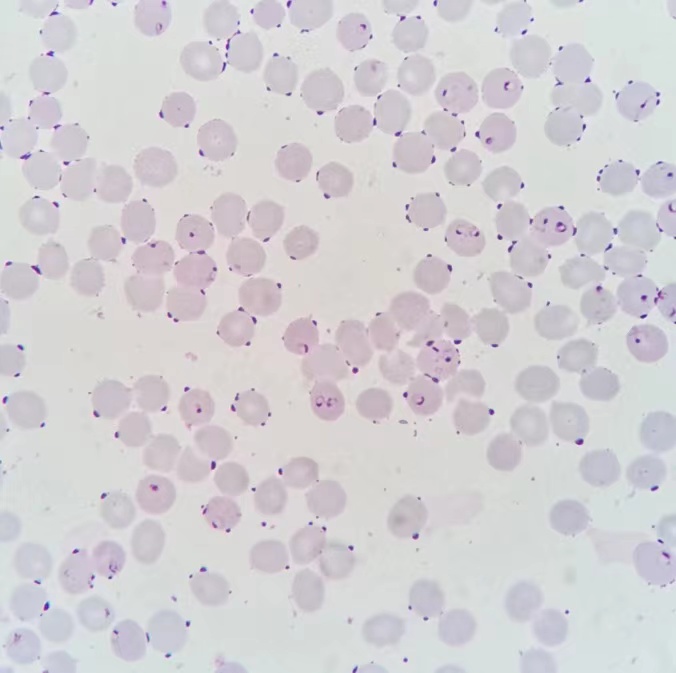
图为恶性疟环状体

|咨询电话
027-85516152 (工作日日间)
15327190618 (夜间节假日)

科普知识
回国后反复发热,竟是因为红细胞里藏着的“戒指”
发布时间:2023-12-19
来源:原创文章
作者:肖楠
字号:



A先生刚刚结束了为期两年的驻非工作回国,没想到回国还没多久,由于反复发热,自行服用了一些感冒药和退烧药却收效甚微,就近来我院就诊。医生仔细询问了症状后,检验申请单和病人的血液样本送到了检验科。
经过检验科医生涂片染色镜检,在高倍的油镜镜头下,患者的红细胞内发现了这样的“戒指”。
这些“戒指”名叫环状体,是疟原虫生活史中一个时期的形态,它的出现,代表着疟疾的确诊。疟疾的诊断和分型主要依靠寒战发热期外周血涂片镜检和快速检测试剂盒。
疟疾是严重危害人类健康的疾病之一。感染人体的疟原虫有四种:间日疟原虫、三日疟原虫、恶性疟原虫、卵形疟原虫。当按蚊刺吸病人或带虫者血液时,疟原虫的配子体在按蚊体内完成受精,经过一系列增殖过程,发育为子孢子。当蚊再吸血时,子孢子随蚊唾液进入人体,侵入人肝细胞并在其中分裂增殖形成裂殖子,后胀破肝细胞,侵入红细胞形成环状体。环状体经过生长发育,经大滋养体、未成熟裂殖体、含有一定数量裂殖子的裂殖体,胀破后再次侵入正常红细胞,重复红细胞内期的裂体增殖过程。红细胞内期的裂体增殖,可以导致表现为“寒战、高热、出汗退热”的周期性的典型疟疾发作。典型的间日疟和卵形疟隔天发作一次,三日疟隔两天发作一次,恶性疟36-48小时发作一次。发作数次后,可引起贫血,脾肿大、甚至凶险性疟疾(持续高热、全身衰竭等)。
派驻疟疾流行区工作的人群建议做好防蚊灭蚊的工作,近期有疟疾流行区旅游工作史的人群,如有反复的寒战、高热、出汗退热症状,应及时就医,以免发展成重症疟疾,延误治疗。
(文:肖楠)
- 上一篇:抽血量对血凝检验结果有影响
- 下一篇:自行留取痰液标本应该注意点什么?


